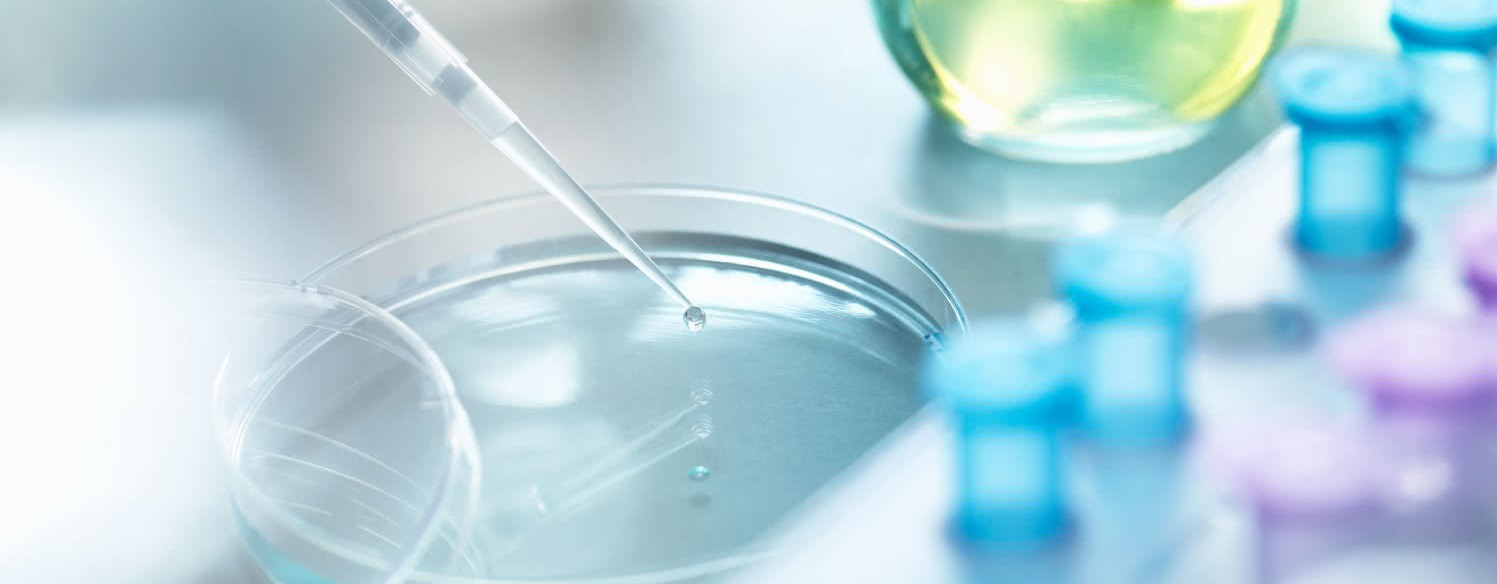

Jsme průkopníky personalizované výživy založené na testování
Ze země polární záře, půlnočního slunce, nejhlubších fjordů a nejstrmějších hor.
Jsme průkopníky personalizované výživy založené na testování
Ze země polární záře, půlnočního slunce, nejhlubších fjordů a nejstrmějších hor.
NAŠE STRATEGIE VÝŽIVY ZALOŽENÁ NA TESTECH
Vaše cesta začíná našimi zdravotními testy. Tak Vás i svět vrátíme zpět do rovnováhy


Vystupte ze tmy. Připojte se k novému standardu osobního zdraví.
S podporou našeho vědeckého poradního sboru a našich interních specialistů na R&D (výzkum a vývoj)
Dr. Emmalee Gisslevik
Hlavní specialista pro výzkum a vývoj (Balance Oil) ve společnosti Zinzino
Dr. Gisslevik má doktorát z potravinářství a výživy a specializuje se na esenciální mastné kyseliny. Zaměřuje se na inovace a vylepšení doplňků stravy s omega-3, aby se vyrovnaly zdravotním účinkům celých ryb.
Dr. Martina Torrissen
Specialista výzkumu a vývoje ve společnosti Zinzino
Dr. Torrissen má doktorát PhD v oboru výživových věd z Norské univerzity přírodních věd. Její výzkum se zaměřuje na biologické funkce VLC-PUFA a zabývá se analýzou profilů omega-3 mastných kyselin z databáze Zinzino, která obsahuje vzorky sušených krvinek.
Dr. Paul Clayton
Hlavní člen Vědecké rady společnosti Zinzino
Dr. Clayton je klinický farmakolog, odborník na farmakologickou výživu a průkopník ve studiu farmakologických účinků potravin a jejich vlivu na zdraví a fyzickou výkonnost. Je držitelem doktorátu z neurofarmakologie na univerzitě v Edinburghu a bývalým předsedou Fóra pro potraviny a zdraví (Velká Británie) a hlavním vědeckým poradcem Výboru pro bezpečnost léčiv při britské vládě.
Ola Eide
Člen Vědecké rady společnosti Zinzino
Pan Eide je zakladatelem společnosti BioActive Foods AS, která je lídrem v oboru. Zastával řadu vedoucích funkcí, byl například předsedou představenstva v norském a severském výzkumném programu v oblasti potravin, ředitelem pro inovace v Mills DA a ředitelem pro výzkum a vývoj v norské mlékárenské společnosti Tine.
Dr. Angela M. Rizzo
Člen Vědecké rady společnosti Zinzino
Dr. Rizzo je odbornicí na biochemické procesy v lipidech. Je profesorkou biochemie na Univerzitě v Miláně. Mezi její četné publikace patří například v Journal of the American College of Nutrition a v Nutrition Journal.
Dr. Martina Torrissen
Specialista výzkumu a vývoje ve společnosti Zinzino
Dr. Torrissen má doktorát PhD v oboru výživových věd z Norské univerzity přírodních věd. Její výzkum se zaměřuje na biologické funkce VLC-PUFA a zabývá se analýzou profilů omega-3 mastných kyselin z databáze Zinzino, která obsahuje vzorky sušených krvinek.
Dr. Paul Clayton
Hlavní člen Vědecké rady společnosti Zinzino
Dr. Clayton je klinický farmakolog, odborník na farmakologickou výživu a průkopník ve studiu farmakologických účinků potravin a jejich vlivu na zdraví a fyzickou výkonnost. Je držitelem doktorátu z neurofarmakologie na univerzitě v Edinburghu a bývalým předsedou Fóra pro potraviny a zdraví (Velká Británie) a hlavním vědeckým poradcem Výboru pro bezpečnost léčiv při britské vládě.
Ola Eide
Člen Vědecké rady společnosti Zinzino
Pan Eide je zakladatelem společnosti BioActive Foods AS, která je lídrem v oboru. Zastával řadu vedoucích funkcí, byl například předsedou představenstva v norském a severském výzkumném programu v oblasti potravin, ředitelem pro inovace v Mills DA a ředitelem pro výzkum a vývoj v norské mlékárenské společnosti Tine.
Dr. Angela M. Rizzo
Člen Vědecké rady společnosti Zinzino
Dr. Rizzo je odbornicí na biochemické procesy v lipidech. Je profesorkou biochemie na Univerzitě v Miláně. Mezi její četné publikace patří například v Journal of the American College of Nutrition a v Nutrition Journal.
Dr. Ananthara J Abraham
Člen Vědecké rady společnosti Zinzino
Dr. Abraham má více než 40letou zkušenost v odvětví zdraví a výživy. V roce 1974 získal titul doktora medicíny a má zkušenosti jak ze státních nemocnic, tak i z různých lékařských oborů. V letech 2016-2019 dr. Abraham pracoval jako firemní lékařský poradce pro společnost Nestle.
Dr. Paul Clayton
Hlavní člen Vědecké rady společnosti Zinzino
Dr. Clayton je klinický farmakolog, odborník na farmakologickou výživu a průkopník ve studiu farmakologických účinků potravin a jejich vlivu na zdraví a fyzickou výkonnost. Je držitelem doktorátu z neurofarmakologie na univerzitě v Edinburghu a bývalým předsedou Fóra pro potraviny a zdraví (Velká Británie) a hlavním vědeckým poradcem Výboru pro bezpečnost léčiv při britské vládě.
Ola Eide
Člen Vědecké rady společnosti Zinzino
Pan Eide je zakladatelem společnosti BioActive Foods AS, která je lídrem v oboru. Zastával řadu vedoucích funkcí, byl například předsedou představenstva v norském a severském výzkumném programu v oblasti potravin, ředitelem pro inovace v Mills DA a ředitelem pro výzkum a vývoj v norské mlékárenské společnosti Tine.
Dr. Angela M. Rizzo
Člen Vědecké rady společnosti Zinzino
Dr. Rizzo je odbornicí na biochemické procesy v lipidech. Je profesorkou biochemie na Univerzitě v Miláně. Mezi její četné publikace patří například v Journal of the American College of Nutrition a v Nutrition Journal.
Dr. Ananthara J Abraham
Člen Vědecké rady společnosti Zinzino
Dr. Abraham má více než 40letou zkušenost v odvětví zdraví a výživy. V roce 1974 získal titul doktora medicíny a má zkušenosti jak ze státních nemocnic, tak i z různých lékařských oborů. V letech 2016-2019 dr. Abraham pracoval jako firemní lékařský poradce pro společnost Nestle.
Stephen Cherniske
Člen Vědecké rady společnosti Zinzino
Stephen Cherniske je biochemik a bývalý vysokoškolský učitel klinické výživy. Vedl klinickou laboratoř pro výživu a imunologii s licencí FDA, působil na fakultě American College of Sports Medicine a podílel se na vytvoření největší knihovny léčivých rostlin na světě.
Ola Eide
Člen Vědecké rady společnosti Zinzino
Pan Eide je zakladatelem společnosti BioActive Foods AS, která je lídrem v oboru. Zastával řadu vedoucích funkcí, byl například předsedou představenstva v norském a severském výzkumném programu v oblasti potravin, ředitelem pro inovace v Mills DA a ředitelem pro výzkum a vývoj v norské mlékárenské společnosti Tine.
Dr. Angela M. Rizzo
Člen Vědecké rady společnosti Zinzino
Dr. Rizzo je odbornicí na biochemické procesy v lipidech. Je profesorkou biochemie na Univerzitě v Miláně. Mezi její četné publikace patří například v Journal of the American College of Nutrition a v Nutrition Journal.
Dr. Ananthara J Abraham
Člen Vědecké rady společnosti Zinzino
Dr. Abraham má více než 40letou zkušenost v odvětví zdraví a výživy. V roce 1974 získal titul doktora medicíny a má zkušenosti jak ze státních nemocnic, tak i z různých lékařských oborů. V letech 2016-2019 dr. Abraham pracoval jako firemní lékařský poradce pro společnost Nestle.
Stephen Cherniske
Člen Vědecké rady společnosti Zinzino
Stephen Cherniske je biochemik a bývalý vysokoškolský učitel klinické výživy. Vedl klinickou laboratoř pro výživu a imunologii s licencí FDA, působil na fakultě American College of Sports Medicine a podílel se na vytvoření největší knihovny léčivých rostlin na světě.
Dr. Natalie Kather
Člen Vědecké rady společnosti Zinzino
Dr. Natalie Kather je lékařka s atestací z rodinného lékařství. Je průkopnicí v nově vznikajícím oboru integrativní medicíny a působila jako hlavní výzkumná pracovnice klinických studií v oblasti farmaceutických i přírodních produktů.
Dr. Angela M. Rizzo
Člen Vědecké rady společnosti Zinzino
Dr. Rizzo je odbornicí na biochemické procesy v lipidech. Je profesorkou biochemie na Univerzitě v Miláně. Mezi její četné publikace patří například v Journal of the American College of Nutrition a v Nutrition Journal.
Dr. Ananthara J Abraham
Člen Vědecké rady společnosti Zinzino
Dr. Abraham má více než 40letou zkušenost v odvětví zdraví a výživy. V roce 1974 získal titul doktora medicíny a má zkušenosti jak ze státních nemocnic, tak i z různých lékařských oborů. V letech 2016-2019 dr. Abraham pracoval jako firemní lékařský poradce pro společnost Nestle.
Stephen Cherniske
Člen Vědecké rady společnosti Zinzino
Stephen Cherniske je biochemik a bývalý vysokoškolský učitel klinické výživy. Vedl klinickou laboratoř pro výživu a imunologii s licencí FDA, působil na fakultě American College of Sports Medicine a podílel se na vytvoření největší knihovny léčivých rostlin na světě.
Dr. Natalie Kather
Člen Vědecké rady společnosti Zinzino
Dr. Natalie Kather je lékařka s atestací z rodinného lékařství. Je průkopnicí v nově vznikajícím oboru integrativní medicíny a působila jako hlavní výzkumná pracovnice klinických studií v oblasti farmaceutických i přírodních produktů.
Dr. Colin Robertson
Produktový ředitel společnosti Zinzino
Dr. Colin Robertson má doktorát PhD z fyziologie cvičení. Jako kvalifikovaný vědec v oblasti výživy a sportu a odborník na cvičení se podílel na vývoji zdravotních strategií a norem po celém světě.
Dr. Ananthara J Abraham
Člen Vědecké rady společnosti Zinzino
Dr. Abraham má více než 40letou zkušenost v odvětví zdraví a výživy. V roce 1974 získal titul doktora medicíny a má zkušenosti jak ze státních nemocnic, tak i z různých lékařských oborů. V letech 2016-2019 dr. Abraham pracoval jako firemní lékařský poradce pro společnost Nestle.
Stephen Cherniske
Člen Vědecké rady společnosti Zinzino
Stephen Cherniske je biochemik a bývalý vysokoškolský učitel klinické výživy. Vedl klinickou laboratoř pro výživu a imunologii s licencí FDA, působil na fakultě American College of Sports Medicine a podílel se na vytvoření největší knihovny léčivých rostlin na světě.
Dr. Natalie Kather
Člen Vědecké rady společnosti Zinzino
Dr. Natalie Kather je lékařka s atestací z rodinného lékařství. Je průkopnicí v nově vznikajícím oboru integrativní medicíny a působila jako hlavní výzkumná pracovnice klinických studií v oblasti farmaceutických i přírodních produktů.
Dr. Colin Robertson
Produktový ředitel společnosti Zinzino
Dr. Colin Robertson má doktorát PhD z fyziologie cvičení. Jako kvalifikovaný vědec v oblasti výživy a sportu a odborník na cvičení se podílel na vývoji zdravotních strategií a norem po celém světě.
Dr. Emmalee Gisslevik
Hlavní specialista pro výzkum a vývoj (Balance Oil) ve společnosti Zinzino
Dr. Gisslevik má doktorát z potravinářství a výživy a specializuje se na esenciální mastné kyseliny. Zaměřuje se na inovace a vylepšení doplňků stravy s omega-3, aby se vyrovnaly zdravotním účinkům celých ryb.
Stephen Cherniske
Člen Vědecké rady společnosti Zinzino
Stephen Cherniske je biochemik a bývalý vysokoškolský učitel klinické výživy. Vedl klinickou laboratoř pro výživu a imunologii s licencí FDA, působil na fakultě American College of Sports Medicine a podílel se na vytvoření největší knihovny léčivých rostlin na světě.
Dr. Natalie Kather
Člen Vědecké rady společnosti Zinzino
Dr. Natalie Kather je lékařka s atestací z rodinného lékařství. Je průkopnicí v nově vznikajícím oboru integrativní medicíny a působila jako hlavní výzkumná pracovnice klinických studií v oblasti farmaceutických i přírodních produktů.
Dr. Colin Robertson
Produktový ředitel společnosti Zinzino
Dr. Colin Robertson má doktorát PhD z fyziologie cvičení. Jako kvalifikovaný vědec v oblasti výživy a sportu a odborník na cvičení se podílel na vývoji zdravotních strategií a norem po celém světě.
Dr. Emmalee Gisslevik
Hlavní specialista pro výzkum a vývoj (Balance Oil) ve společnosti Zinzino
Dr. Gisslevik má doktorát z potravinářství a výživy a specializuje se na esenciální mastné kyseliny. Zaměřuje se na inovace a vylepšení doplňků stravy s omega-3, aby se vyrovnaly zdravotním účinkům celých ryb.
Dr. Martina Torrissen
Specialista výzkumu a vývoje ve společnosti Zinzino
Dr. Torrissen má doktorát PhD v oboru výživových věd z Norské univerzity přírodních věd. Její výzkum se zaměřuje na biologické funkce VLC-PUFA a zabývá se analýzou profilů omega-3 mastných kyselin z databáze Zinzino, která obsahuje vzorky sušených krvinek.
Dr. Natalie Kather
Člen Vědecké rady společnosti Zinzino
Dr. Natalie Kather je lékařka s atestací z rodinného lékařství. Je průkopnicí v nově vznikajícím oboru integrativní medicíny a působila jako hlavní výzkumná pracovnice klinických studií v oblasti farmaceutických i přírodních produktů.
Dr. Colin Robertson
Produktový ředitel společnosti Zinzino
Dr. Colin Robertson má doktorát PhD z fyziologie cvičení. Jako kvalifikovaný vědec v oblasti výživy a sportu a odborník na cvičení se podílel na vývoji zdravotních strategií a norem po celém světě.
Dr. Emmalee Gisslevik
Hlavní specialista pro výzkum a vývoj (Balance Oil) ve společnosti Zinzino
Dr. Gisslevik má doktorát z potravinářství a výživy a specializuje se na esenciální mastné kyseliny. Zaměřuje se na inovace a vylepšení doplňků stravy s omega-3, aby se vyrovnaly zdravotním účinkům celých ryb.
Dr. Martina Torrissen
Specialista výzkumu a vývoje ve společnosti Zinzino
Dr. Torrissen má doktorát PhD v oboru výživových věd z Norské univerzity přírodních věd. Její výzkum se zaměřuje na biologické funkce VLC-PUFA a zabývá se analýzou profilů omega-3 mastných kyselin z databáze Zinzino, která obsahuje vzorky sušených krvinek.
Dr. Paul Clayton
Hlavní člen Vědecké rady společnosti Zinzino
Dr. Clayton je klinický farmakolog, odborník na farmakologickou výživu a průkopník ve studiu farmakologických účinků potravin a jejich vlivu na zdraví a fyzickou výkonnost. Je držitelem doktorátu z neurofarmakologie na univerzitě v Edinburghu a bývalým předsedou Fóra pro potraviny a zdraví (Velká Británie) a hlavním vědeckým poradcem Výboru pro bezpečnost léčiv při britské vládě.
Dr. Colin Robertson
Produktový ředitel společnosti Zinzino
Dr. Colin Robertson má doktorát PhD z fyziologie cvičení. Jako kvalifikovaný vědec v oblasti výživy a sportu a odborník na cvičení se podílel na vývoji zdravotních strategií a norem po celém světě.
Dr. Emmalee Gisslevik
Hlavní specialista pro výzkum a vývoj (Balance Oil) ve společnosti Zinzino
Dr. Gisslevik má doktorát z potravinářství a výživy a specializuje se na esenciální mastné kyseliny. Zaměřuje se na inovace a vylepšení doplňků stravy s omega-3, aby se vyrovnaly zdravotním účinkům celých ryb.
Dr. Martina Torrissen
Specialista výzkumu a vývoje ve společnosti Zinzino
Dr. Torrissen má doktorát PhD v oboru výživových věd z Norské univerzity přírodních věd. Její výzkum se zaměřuje na biologické funkce VLC-PUFA a zabývá se analýzou profilů omega-3 mastných kyselin z databáze Zinzino, která obsahuje vzorky sušených krvinek.
Dr. Paul Clayton
Hlavní člen Vědecké rady společnosti Zinzino
Dr. Clayton je klinický farmakolog, odborník na farmakologickou výživu a průkopník ve studiu farmakologických účinků potravin a jejich vlivu na zdraví a fyzickou výkonnost. Je držitelem doktorátu z neurofarmakologie na univerzitě v Edinburghu a bývalým předsedou Fóra pro potraviny a zdraví (Velká Británie) a hlavním vědeckým poradcem Výboru pro bezpečnost léčiv při britské vládě.
Ola Eide
Člen Vědecké rady společnosti Zinzino
Pan Eide je zakladatelem společnosti BioActive Foods AS, která je lídrem v oboru. Zastával řadu vedoucích funkcí, byl například předsedou představenstva v norském a severském výzkumném programu v oblasti potravin, ředitelem pro inovace v Mills DA a ředitelem pro výzkum a vývoj v norské mlékárenské společnosti Tine.
Náš test ze suché kapky krve Vám poskytne přesná fakta o aktuálním zdravotním stavu.

Společnost Vitas je světovou jedničkou v oblasti testování z kapek krve, smluvní laboratoří s certifikací GMP pro chemickou analýzu.

1,603,212 BalanceTestů provedených k tomuto datu
NÁŠ KONCEPT ROVNOVÁHY
Náš vzorec je skutečnou přírodní silou.
A olivový olej mění pravidla hry
Proto má BalanceOil+ blíže k tučným rybám než k rybímu oleji.
Proto má BalanceOil+ blíže k tučným rybám než k rybímu oleji.
NÁŠ KONCEPT ROVNOVÁHY
Podporováno vědou.
Poháněno přírodou
NÁŠ KONCEPT ROVNOVÁHY
Podporováno vědou.
Poháněno přírodou
NAŠE TESTY & DOPLŇKY
Testy odhalují jedinečné poznatky. Naše doplňky zvládnou každou jejich část
Jeden malý BalanceShot.
Kvantový skok pro lidské zdraví
Jeden malý BalanceShot.
Kvantový skok pro lidské zdraví
Začněte s odebíráním pro lepší život
Zdravější způsob života nemá rychlé řešení. Předplatné dává našim doplňkům čas na jejich práci. Dodávky do domu každý druhý měsíc dávají naší planetě čas na odpočinek.

Naši partneři jsou po celou dobu s Vámi
Součástí předplatného je vždy osobní poradce. Někdo, kdo bude sledovat Vaše pokroky a udržovat Vás na správné cestě, dokud nedosáhnete svých zdravotních cílů.


